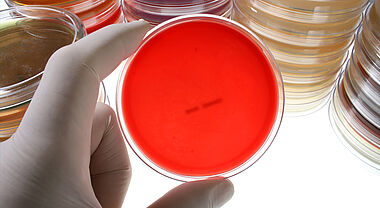

Une reconnaissance de l’excellence, de la diversité et de l’impact de notre corps professoral
Bonne nouvelle ! Le 22 octobre dernier, le gouvernement du Canada a annoncé le renouvellement de quatre Chaires de recherche du Canada détenues par des membres du corps professoral de la Faculté de médecine.
Ce renouvellement témoigne de la qualité et de la portée des travaux menés à la Faculté. Ces chaires jouent un rôle essentiel dans le développement de connaissances de pointe et dans le renforcement de la recherche universitaire au Québec comme au Canada.
« Félicitations à nos quatre titulaires pour cette reconnaissance bien méritée. Leur rigueur scientifique, l’aspect novateur de leurs travaux ainsi que leur engagement envers la formation de la relève contribuent à faire rayonner notre Faculté et à améliorer la santé des populations », souligne Catherine Mercier, vice-doyenne à la recherche et à l’innovation.
Les personnes titulaires sont :
- Marie-Annick Clavel, professeure titulaire au Département de médecine, Chaire de recherche du Canada en santé cardiaque et valvulaire des femmes.
- Étienne Audet-Walsh, professeur agrégé au Département de médecine moléculaire, Chaire de recherche du Canada sur les vulnérabilités métaboliques des cancers.
- Ayman El Ali, professeur titulaire au Département de psychiatrie et de neurosciences, Chaire de recherche du Canada sur les interactions neurovasculaires moléculaires et cellulaires.
- François Bordeleau, professeur agrégé au Département de biologie moléculaire, de biochimie médicale et de pathologie, Chaire de recherche du Canada en mécanorégulation cellulaire.